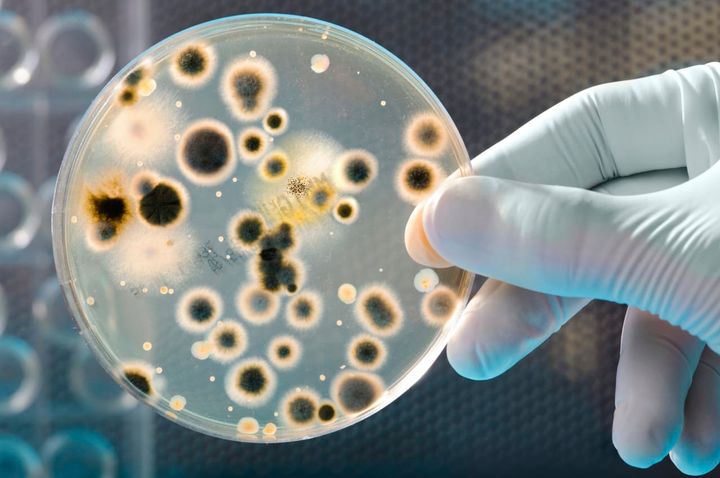

Avföringstransplantation prövas på brännskadade i världsunik studie på Akademiska
– Risken att drabbas av infektioner med resistenta bakterier är hög hos svårt brännskadade. De har ofta stora sår och saknar hudlager som normalt fungerar som en skyddande barriär. Dessutom vårdas patienterna ofta länge i respirator inom intensivvården. Sårinfektioner och blodförgiftning är vanligt förekommande, säger Hanna Montelin, infektionsläkare på Akademiska sjukhuset och doktorand vid Uppsala universitet.
Främsta syftet med patientstudien, menar hon är att se hur tarmfloran och förekomsten av resistenta bakterier förändras under vårdtiden. Forskarna vill även undersöka hur antibiotikabehandling påverkar tarmfloran och effekter av behandling med avföringstransplantation, så kallad fecestransplantation, efter avslutad antibiotikabehandling. Studien görs i samarbete med infektionskliniken och beräknas pågå under två år.
Under senare år har kopplingen mellan tarmflorans sammansättning och förhöjd risk att drabbas av övervikt, hjärt-kärlsjukdomar och diabetes blivit allt tydligare. Sambandet mellan tarmflora, resistenta bakterier, antibiotikabehandling och infektionskänslighet hos brännskadade patienter är däremot mindre utforskat. Men en nyligen publicerad studie har bekräftat att tarmfloran påverkas vid allvarliga brännskador och att det finns ett samband mellan graden av rubbad tarmflora, omfattningen av inflammation och organsvikt. Slutsatsen är att patienter som har en mer intakt tarmflora kan ha ett mer välfungerat immunförsvar och därmed bättre skydd mot blodförgiftning med problem med organfunktion.
I studien kommer tarmfloran undersökas vid ankomst, utskrivning och efter utskrivning. En del av avföringsproverna skickas till mikrobiologen på Akademiska sjukhuset för analys av multiresistenta bakterier. Den andra delen fryses ned och skickas till Scilifelab i Stockholm för kartläggning av tarmflorans sammansättning med hjälp av nya sekvenseringstekniker. En grupp patienter kommer dessutom att få ett lavemang baserat på deras egen ursprungliga avföring i syfte att återskapa normal bakterieflora. Det är första gången sådan behandling ges till brännskadepatienter. Den har tidigare visat sig framgångsrik vid behandling av diarré orsakad av bakterien Clostridium difficile.
– Den som får en rubbad tarmflora och blir bärare av antibiotikaresistenta bakterier kan få problem senare, till exempel med svårbehandlade infektioner. Därför är det värdefullt att se om denna patientgrupp kan ha nytta av transplantationsbehandling, säger Hanna Montelin.
Mer information:
Hanna Montelin, doktorand och infektionsläkare Akademiska sjukhuset, 018-611 17 21
Thomas Grenholm Tängdén, infektionsläkare och forskare vid Uppsala universitet, 018-471 6613
Fredrik Huss, överläkare brännskadecentrum, 018-611 37 57 eller 0738-670483
Bildtext: Agarplatta med odlade bakterier (Istockphoto)
FAKTA: Tarmflorestudie på brännskadepatienter, Akademiska sjukhuset
* Startar i mitten av december på brännskadecentrum, Akademiska sjukhuset.
* Beräknas pågå under två år och inkludera 40-50 patienter över 18 år som vårdas inneliggande för svåra brännskador.
* Hos samtliga kommer tarmfloran undersökas både vid ankomst, utskrivning samt 1, 3 och 6 månader efter utskrivningen. Vid inskrivningen tas ett avföringsprov för undersökning av förekomst av multiresistenta bakterier och tarmflorans sammansättning. * Vissa patienter kommer fyra veckor efter utskrivning att få ett lavemang med den egna ursprungliga tarmfloran som kan återskapa en normal bakterieflora.
Nyckelord
Kontakter
Elisabeth TyskPresschef - Ansvarig för medierelaterade frågor på kommunikationsavdelningen
Akademiska sjukhuset har inte pressjour utanför kontorstid. Vid förfrågningar kvällar och helger, till exempel gällande presskommuniké vid olycksfall, kan chefsläkarjouren kontaktas via växeln 018-611 00 00.
Bilder


Länkar
Om
Akademiska sjukhuset erbjuder specialiserad och högspecialiserad vård lokalt, regionalt, nationellt och internationellt.
Sjukhuset har cirka 8 400 medarbetare, varav 1 500 läkare och 2 750 sjuksköterskor/barnmorskor.
Sjukhuset har 850 vårdplatser. Här görs varje år cirka 722 000 öppenvårdsbesök, 45 300 slutenvårdstillfällen och 32 200 operationer.
Följ Akademiska sjukhuset
Abonnera på våra pressmeddelanden. Endast mejladress behövs och den används bara här. Du kan avanmäla dig när som helst.
Senaste pressmeddelandena från Akademiska sjukhuset
Sjukhusvård i hemmet - nytt alternativ för patienter inom infektion och kirurgi16.12.2025 09:00:00 CET | Pressmeddelande
En ny avdelning har öppnats på Akademiska sjukhuset - Akademiska hemma – som till en början ska erbjuda sjukhusvård i hemmet för patienter inom infektion och kirurgi. Genom att använda modern teknik och medicinska resurser kan patienter, som normalt sett skulle vara inlagda på sjukhuset, i stället få motsvarande vård i hemmet. Satsningen är ett led i arbetet med Effektiv och nära vård; att vården ska flyttas närmare patienterna.
Hälsoriskbedömning klar: Falubors exponering för metaller har undersökts10.12.2025 16:00:00 CET | Pressmeddelande
Faluns tusenåriga historia av gruvdrift har satt omfattande spår i landskapet. Metaller som spridits från gruvdriften finns i dag i marken och kan påverka både miljö och hälsa. Under 2023 startade därför en omfattande undersökning av den förorenade marken i Falun. De preliminära resultaten visar bland annat att en liten mängd nedsvald jord i de mest förorenade områdena kan innebära risk för akut förgiftning.
Uppdaterad: Misstänkt för förgiftningarna häktad för grov misshandel8.12.2025 12:04:54 CET | Pressmeddelande
En person som är anställd vid Akademiska sjukhuset greps och anhölls under helgen. Måndagen den 8 december häktade domstolen på åklagarens begäran personen, skäligen misstänkt för grov misshandel genom förgiftning av fyra personer på Akademiska barnsjukhuset.
En person anhållen misstänkt för förgiftningarna6.12.2025 14:26:13 CET | Pressmeddelande
I början av november inledde polisen en förundersökning om försök till mord med misstanke om förgiftning. Detta efter att fyra medarbetare på samma avdelning på Akademiska barnsjukhuset insjuknat med liknande symtom under arbetstid. Idag har åklagare meddelat att man har gripit och anhållit en misstänkt person.
Nutrition vid kronisk njursjukdom – fokus för internationellt symposium i Uppsala28.11.2025 08:00:00 CET | Pressmeddelande
På Akademiska sjukhuset läggs allt större vikt vid individuellt anpassad nutrition för patienter med kronisk njursjukdom. Detta sker bäst i ett multidisciplinärt samarbete mellan dietister, sjuksköterskor, läkare och forskare. Detta lyfts fram under ett internationellt symposium i Uppsala 30 november-1 december.
I vårt pressrum kan du läsa de senaste pressmeddelandena, få tillgång till pressmaterial och hitta kontaktinformation.
Besök vårt pressrum
